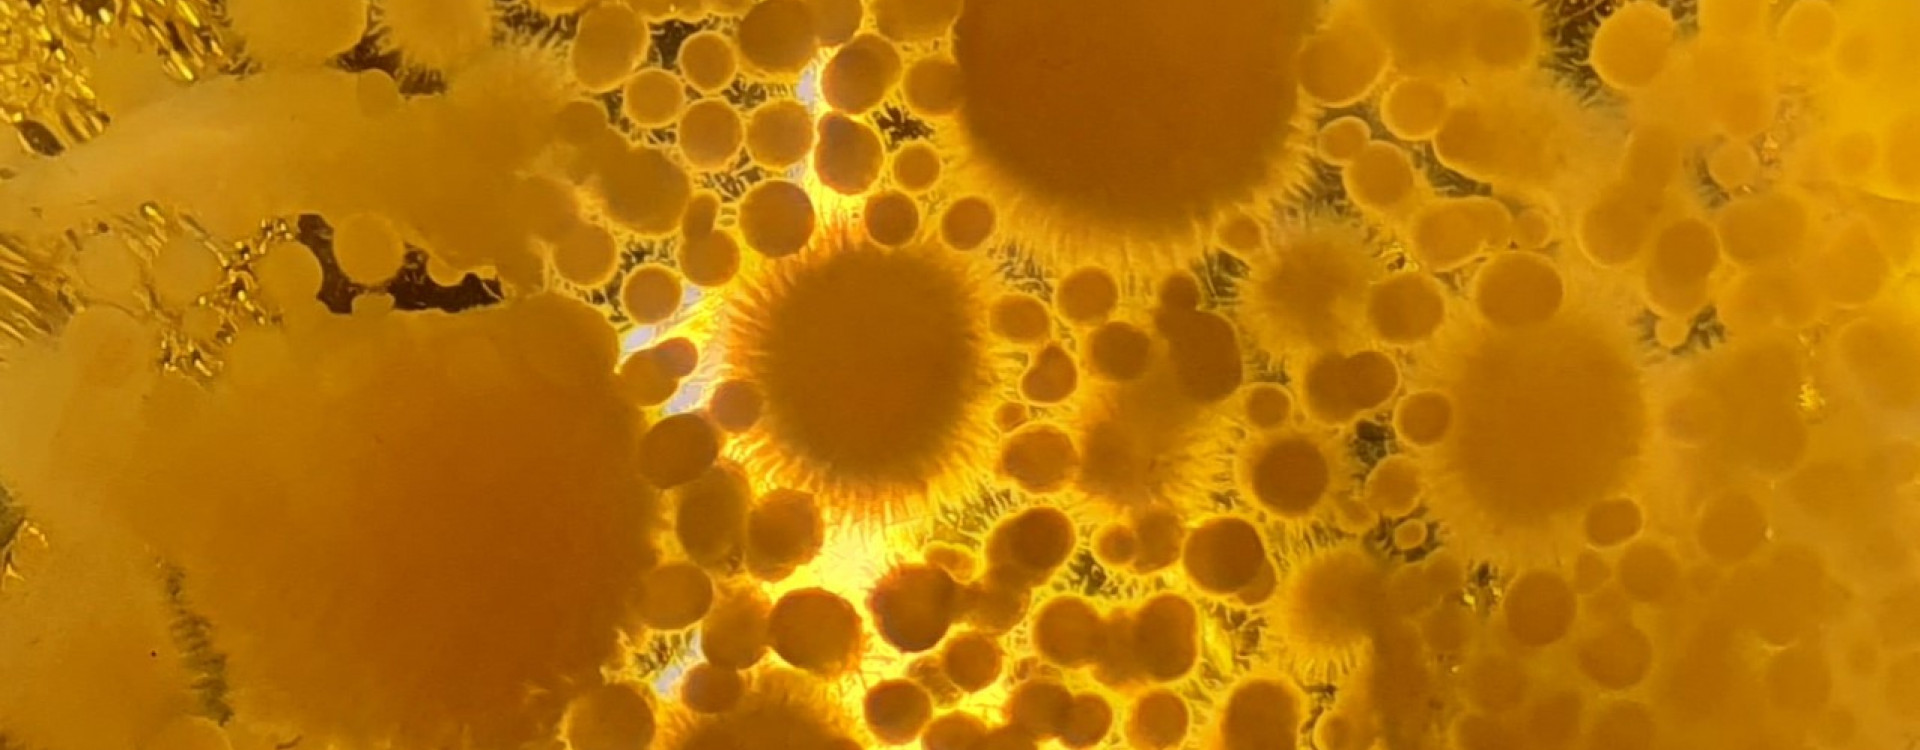
Food Source
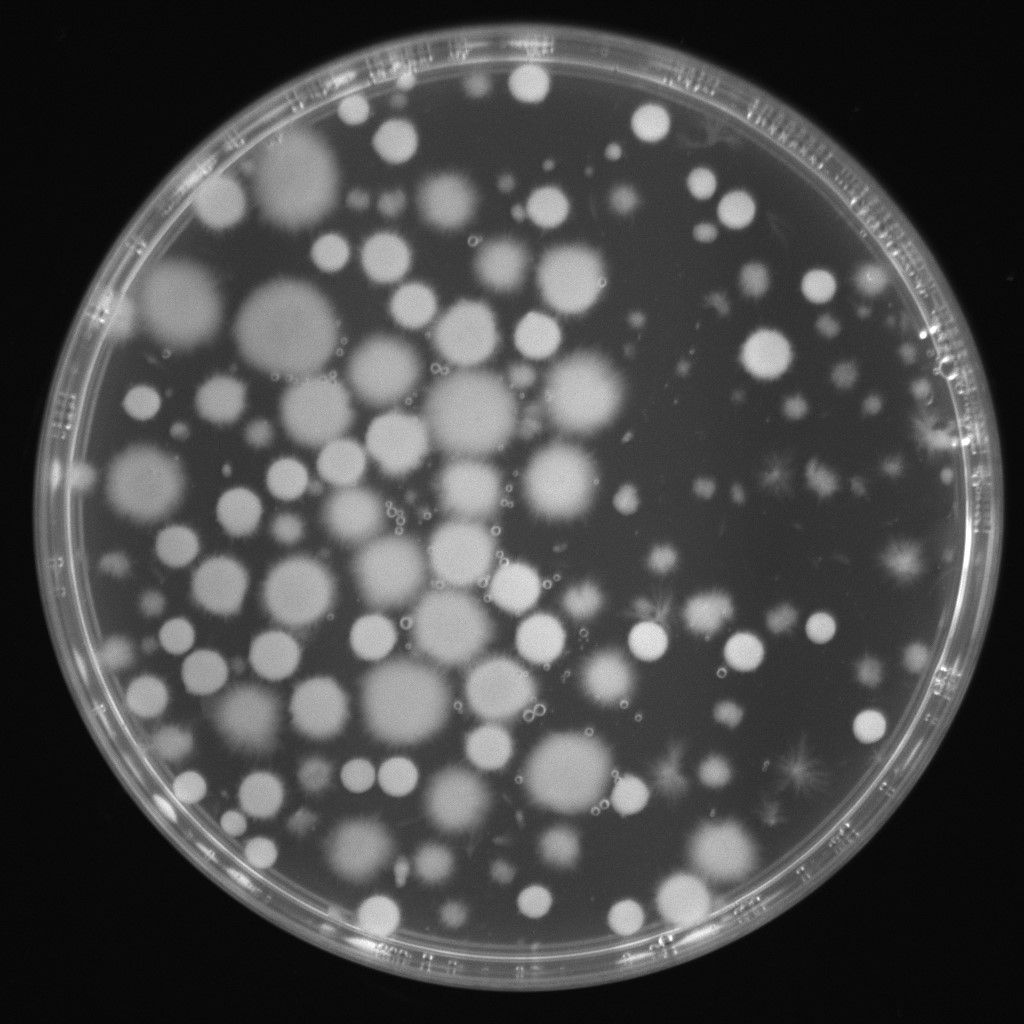
Food Source

Institute for Applied Biotechnology

Project leader: Prof. Dr. techn. Heike Frühwirth
Duration: 2023 –
Project description:
Fungi, especially basidiomycetes, have exciting biotechnology properties. For example, they can metabolize by‐products of the food and agricultural industries. Cultivating the mycelium of these fungi in liquid culture produces pellets rich in protein and fiber. These pellets can be used directly in meat substitutes or other foods.
Due to their filamentous structure, they offer advantages not only in terms of nutritional value but also in terms of texture. Our project is concerned with optimizing the cultivation of such basidiomycetes to save byproducts from waste and return them to the value chain.

Project data sheet for download: